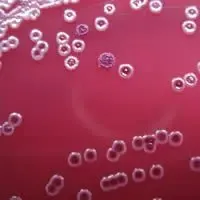
Colonie a diversa morfologia di Burkholderi pseudomallei

Loretta Sebastiani

Argomenti pubblicati in IGIENE e PATOLOGIA
Igiene e patologia
La storia dell'igiene
Il concetto di pulizia dall'antica Roma al Medioevo, dal Rinascimento all'Età Moderna.
Igiene e patologia
Le malattie del sistema nervoso
Alzheimer, Parkinson,
neurofibromatosi, sclerosi multipla
sclerosi tuberosa, sclerosi laterale amiotrofica
Igiene e Patologia
Dai barbieri ai chirurghi
Breve storia della chirurgia dal medioevo al IXX secolo.
Igiene e patologia
Malattie genetiche da anomalie numeriche di cromosomi
Sindrome della tripla X
Sindrome di Turner
Sindrome di Klinefelter
Sindrome di Down
Igiene e patologia
Malattie genetiche da aberrazioni cromosomiche
Sindrome del grido del gatto
Sindrome di Wolf
Igiene e patologia
Malattie ereditarie legate al sesso
Emofilia
Daltonismo
Sindrome dell'X fragile
Distrofia muscolare di Duchenne
Igiene e patologia
Malattie genetiche
Variabilità genetica e regolazione epigenetica
Classificazione
Malattie ereditarie e congenite
Igiene e patologia
Malattie genetiche autosomiche recessive
Albinismo
Fenilchetonuria
Fibrosi cistica
Talassemia
Anemia falciforme
Malattia di Tay-Sachs
Igiene e patologia
Diabete
Glucosio, insulina e glucagone
Diabete di tipo 1 e 2, diabete gestazionale
Fattori di rischio
Diagnosi e terapia
Epidemiologia e prevenzione
Igiene e patologia
Cancro al polmone
Classificazione istologica
Sintomi, diagnosi e terapia
Epidemiologia e prevenzione
Igiene e patologia
Il linfoma di Hodgkin
Le cellule di Reed-Sternberg
Diagnosi e terapia
Fattori di rischio
Epidemiologia e prevenzione
Igiene e patologia
Il cancro
Cancerogenesi mutazionale ed epigenetica
Metastasi
Fattori di rischio
Epidemiologia e prevenzione
Stadiazione
Virus oncogeni
Diagnosi e terapia
Alcuni tipi di neoplasie maligne
Igiene e patologia
Le sostanze stupefacenti
Ipnotico-sedativi, allucinogeni, stimolanti narcotici, cannabis.
Igiene e patologia
Fattori causali di malattia: abitudini personali - alcolismo
Storia, alcol etilico, gradazione alcolica, calcolo tasso alcolemico, patologie alcol-correlate, epidemiologia e prevenzione, tossicocinetica e tossicodinamica dell'alcol etilico
Igiene e patologia
Fattori causali di malattia: alimentazione scorretta e sedentarietà
Epidemiologia e prevenzione
Igiene e patologia
Fattori causali di malattia: tabagismo
La nicotina e il suo meccanismo d'azione.
Le altre molecole dannose
Gli effetti sula salute
Le strategie delle multinazionali del tabacco per indurre la gente a fumare.
Igiene e patologia
Fattori causali di malattia
Fattori ambientali, biologici e di comportamento individuale
Igiene e patologia
Fattori causali di malattia: le radiazioni
Radiazioni ionizzanti e non, fonti.
Danni molecolari e biologici.
Dose equivalente ed efficace.
Danni a tessuti ed organi.
Igiene e patologia
Malattie cardiovascolari
Ischemia, arteriosclerosi, aterosclerosi
Infarto del miocardio
Ipertensione e altre concause
Prevenzione
Igiene e patologia
Fattori causali di malattia
Inquinamento acustico
Definizione di suono e sua propagazione, pressione sonora, sorgenti di rumore e dB, effetti sula salute
Igiene e patologia
Antrace - Carbonchio
Descrizione dell'agente eziologico: Bacillus anthracis
Malattia, diagnosi, terapia, epidemiologia
Do you CLIL? Anthrax surface sampling
Igiene e patologia
Fattori causali di malattia: inquinamento indoor
Definizione, leggi, inquinanti, malattie.
Do you CLIL? Eco-friendly house building tips
Spunti per approfondimenti
Igiene e patologia
Giardiasi
Zoonosi dovuta a Giardia lamblia
Agente eziologico, malattia, diagnosi
Terapia, epidemiologia e prevenzione
Igiene e patologia
Fattori causali di malattia
Suolo e inquinamento
Cause e conseguenze
Inquinanti organici e inorganici
Igiene - Malattie infettive
Il colera
La storia della scoperta dell'agente eziologico: Vibrio cholerae<
La malattia, epidemiologia e prevenzione
CLIL: Dr. Robin's tips on cholera disease
Igiene. Rischi per la salute.
I terremoti
Impatto immediato, a medio e breve termine.
Radon e terremoti
Mascherina si o no per gli operatori?
I cadaveri sono un problema sanitario?
Attività CLIL